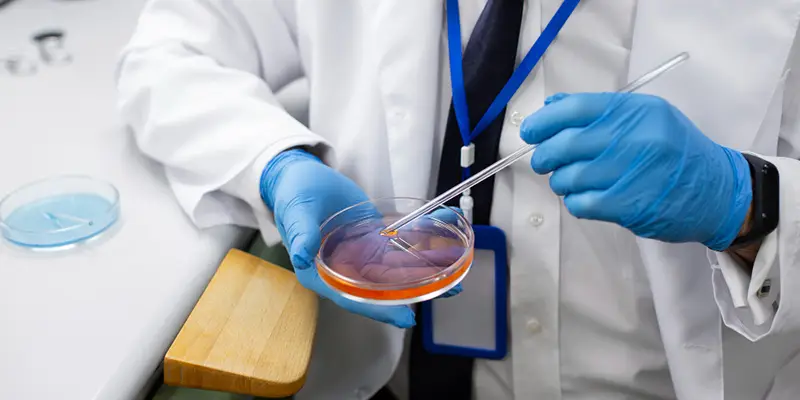

Imagina que estás a punto de realizar el viaje más importante de tu vida. Tienes el mapa, las maletas listas y el destino claro: abrazar a tu hijo. Pero, justo antes de partir, alguien te ofrece una «lupa mágica». Esta lupa puede mirar dentro de las semillas de vida que has creado y decirte cuáles tienen más probabilidades de florecer y cuáles podrían marchitarse en el camino. Sin embargo, usar esta lupa tiene un precio y un pequeño riesgo: ¿podría la lupa dañar la semilla al mirarla tan de cerca? Esta es la duda que quita el sueño a miles de familias que recurren a la gestación subrogada: ¿Debemos hacer la biopsia embrionaria o dejar que la naturaleza siga su curso? Quédate hasta el final, porque la respuesta no es la misma para todos y conocer el detalle técnico podría cambiar radicalmente tu tasa de éxito.
¿Qué es exactamente la biopsia embrionaria?
Cuando hablamos de maternidad subrogada, el proceso técnico suele implicar una Fecundación In Vitro (FIV). Una vez que los óvulos son fecundados por los espermatozoides en el laboratorio, se convierten en embriones.
La biopsia embrionaria, conocida técnicamente como Test Genético Preimplantacional (PGT), consiste en extraer unas pocas células del embrión para analizarlas genéticamente antes de que sean transferidos a la gestante. Es como hacer un «examen médico» al embrión cuando solo tiene unos pocos días de vida.
Técnicas detalladas para realizar la biopsia de los embriones
Para entender las ventajas de realizar biopsia a los embriones antes de realizar la transferencia embrionaria, primero debemos comprender cómo se hace. No es una técnica única; ha evolucionado mucho con los años.
1. Biopsia en día 3 (Estadio de células)
Hace años, se hacía cuando el embrión tenía solo 8 células. Se extraía una célula (blastómero).
- El problema: El embrión perdía el 12% de su masa. Era muy invasivo. Hoy en día, en los procesos modernos de gestación subrogada, esta técnica está casi en desuso porque puede comprometer la viabilidad del futuro bebé.
2. Biopsia de Trofoectodermo (Día 5 o 6 – Blastocisto)
Es el estándar de oro actual. El embrión ya tiene cientos de células y se ha dividido en dos partes: la masa celular interna (que será el bebé) y el trofoectodermo (que será la placenta).
- Cómo se hace: Se utiliza un láser de alta precisión para hacer una pequeña apertura en la «cáscara» del embrión (zona pelúcida) y se aspiran entre 5 y 10 células del trofoectodermo.
- Seguridad: Al no tocar la masa celular interna, el riesgo para el futuro bebé es mucho menor.
3. Biopsia no invasiva (PGT-A)
Esta es la técnica más vanguardista. En lugar de «pinchar» el embrión, los científicos analizan el ADN que el embrión libera de forma natural en el líquido donde está flotando (medio de cultivo). Aunque es prometedora, todavía no es tan precisa como la biopsia directa.
Ventajas de realizar biopsia a los embriones antes de la transferencia embrionaria
Si estás investigando sobre la gestación subrogada, sabrás que cada intento de transferencia tiene un coste emocional y económico muy alto. Aquí es donde la biopsia brilla.
1. Aumento de la tasa de embarazo por transferencia
No todos los embriones que parecen «bonitos» al microscopio son genéticamente sanos. Un embrión puede tener un aspecto perfecto pero tener un número incorrecto de cromosomas (aneuploide). Al seleccionar solo los embriones sanos (euploides), las probabilidades de que la gestante quede embarazada a la primera aumentan significativamente.
2. Reducción del riesgo de aborto espontáneo
La causa principal de los abortos en el primer trimestre son las anomalías cromosómicas. Al descartar embriones con estas fallas, protegemos a la gestante de un proceso físico y emocional tan duro como es un aborto, algo vital en la ética de la gestación subrogada.
3. Información sobre el sexo del embrión
Este es uno de los argumentos si es positivo de realizar la biopsia de embriones, ya que también sabremos el sexo del mismo embrión aparte de saber que no tiene anomalías. En muchos países donde se realiza la maternidad subrogada, como Estados Unidos, los padres pueden elegir el sexo por equilibrio familiar. Saber que tu futuro hijo está sano y, además, conocer si será niño o niña, aporta una capa de seguridad y planificación extra para las familias.
4. Detección de enfermedades monogénicas
Si los padres biológicos son portadores de una enfermedad grave (como la fibrosis quística), la biopsia permite identificar qué embriones no han heredado la enfermedad.
Desventajas de realizar biopsia a los embriones antes de la transferencia embrionaria
No todo es color de rosa. Existen desventajas de realizar biopsia a los embriones antes de realizar la transferencia embrionaria que deben ser evaluadas con calma.
1. El riesgo de daño al embrión
Aunque con la técnica de día 5 el riesgo es bajo (menos del 1%), sigue existiendo la posibilidad de que el embrión no sobreviva al proceso de biopsia o a la posterior congelación (vitrificación) que se requiere mientras se esperan los resultados.
2. El fenómeno del mosaicismo
A veces, un embrión tiene una mezcla de células sanas y células con anomalías. Esto se llama mosaico. La biopsia podría tomar solo las células malas de un embrión que, en realidad, era capaz de «repararse» solo y dar lugar a un bebé sano. Esto podría llevarnos a descartar embriones que podrían haber sido hijos sanos.
3. El coste económico
En un proceso de gestación subrogada, los gastos se acumulan. La biopsia genética puede añadir entre 3.000€ y 6.000€ al presupuesto total, dependiendo del número de embriones analizados.
4. Menos embriones disponibles para transferir
Es posible que, tras la biopsia, descubras que ninguno de tus embriones es apto. Esto es un golpe anímico muy fuerte, aunque algunos expertos argumentan que es mejor saberlo antes de gastar dinero y esperanza en una transferencia condenada al fracaso.
¿Cuándo se recomienda realizar la biopsia de embriones?
No todos los pacientes de gestación subrogada necesitan una biopsia. Los médicos suelen recomendarla en casos específicos:
- Edad materna avanzada: Cuando la madre biológica o la donante de óvulos tiene más de 35-37 años.
- Abortos de repetición: Si ya han existido pérdidas previas.
- Fallos de implantación: Si se han transferido embriones buenos anteriormente y no hubo embarazo.
- Factor masculino severo: Cuando el semen presenta anomalías genéticas.
- Deseo de los padres: Simplemente por la tranquilidad de saber que se está transfiriendo el embrión con mayor potencial.
Debate a favor de realizar esta técnica
El debate a favor de realizar esta técnica se centra en la ética y la eficiencia.
Por un lado, los defensores sostienen que es más ético transferir un embrión con altas garantías de salud, evitando así el sufrimiento de la gestante ante un posible aborto o la decisión de una interrupción del embarazo por malformaciones graves.
Por otro lado, la eficiencia económica en la maternidad subrogada es clave. Aunque la biopsia es cara, realizar tres transferencias fallidas es mucho más caro (y doloroso) que hacer una sola transferencia de un embrión testado genéticamente.

El proceso paso a paso en un entorno de gestación subrogada
Si decides avanzar con la gestación subrogada y la biopsia, este será el camino:
- Estimulación y punción: Se obtienen los óvulos de la madre o donante.
- Fecundación: Se crean los embriones en el laboratorio.
- Cultivo hasta Blastocisto: Se espera a que los embriones lleguen al día 5 o 6.
- La Biopsia: El embriólogo extrae las células.
- Vitrificación: Los embriones se congelan inmediatamente.
- Análisis: Las células se envían a un laboratorio de genética. Los resultados tardan entre 10 y 15 días.
- Preparación de la gestante: Una vez identificado el embrión sano (y el sexo, si se desea), se prepara el útero de la gestante.
- Transferencia: Se descongela el embrión seleccionado y se transfiere.
Conclusión: ¿Vale la pena?
La decisión de realizar una biopsia a tus embriones en un proceso de gestación subrogada es profundamente personal. Si buscas la máxima seguridad, quieres reducir tiempos y evitar sufrimientos innecesarios a la gestante, la ciencia está de tu parte. Si tienes pocos embriones y te da miedo el riesgo técnico del laboratorio, quizás prefieras la transferencia directa.
En la Asociación de Padres por la Gestación Subrogada , acompañamos a las familias en estas decisiones, ofreciendo información veraz y apoyo emocional. Porque al final del día, lo único que importa es que ese camino, por largo que sea, termine con una sonrisa en casa.
Referencias y Citas Contrastadas
- Sociedad Española de Fertilidad (SEF): «El PGT-A es una herramienta eficaz para mejorar la tasa de recién nacido vivo por transferencia, especialmente en pacientes de edad avanzada.»
- ASRM (American Society for Reproductive Medicine): Indica que la biopsia de trofoectodermo en estadio de blastocisto tiene un impacto mínimo en el potencial de implantación del embrión.
- Estudios de la Clínica IVI: Han demostrado que el cribado genético reduce la tasa de aborto en procesos de gestación subrogada hasta en un 50%.
FAQs (Preguntas Frecuentes)
- ¿La biopsia puede causar defectos de nacimiento en mi hijo?
No. Las células se extraen de la parte que formará la placenta, no del bebé. Miles de niños han nacido mediante esta técnica sin que se haya registrado un aumento en defectos de nacimiento respecto a la población general. - ¿Es 100% seguro que el embrión no tendrá ninguna enfermedad?
No existe el 100% en medicina. La biopsia detecta anomalías en el número de cromosomas y enfermedades genéticas específicas, pero no puede detectar todas las posibles condiciones de salud o enfermedades que surjan después del nacimiento. - ¿Puedo elegir el sexo de mi bebé con la biopsia en cualquier país?
No. En España, por ejemplo, la selección de sexo por razones no médicas está prohibida. Sin embargo, en destinos comunes de vientre de alquiler como Estados Unidos, es una práctica legal y habitual. - ¿Qué pasa si todos mis embriones salen «anormales» tras la biopsia?
En ese caso, los médicos recomendarán no realizar la transferencia. Aunque es una noticia triste, evita que la gestante pase por un embarazo que no llegaría a término, permitiendo a los padres decidir si quieren realizar un nuevo ciclo. - ¿Es necesario congelar los embriones para hacer la biopsia?
Sí, actualmente es lo más común. Como el análisis genético tarda unos días, los embriones deben ser congelados (vitrificados) mientras se esperan los resultados. Las tasas de supervivencia a la descongelación son hoy superiores al 95%.
Explicación de las diferentes pruebas genéticas
Es muy común confundirse con estas siglas porque todas suenan parecidas y ocurren dentro del laboratorio de genética, pero sirven para cosas muy distintas. Para entenderlo fácil, imagina que estás revisando un libro (el ADN del embrión) antes de decidir si lo vas a leer (transferirlo a la gestante).
Aquí tienes las diferencias explicadas de forma sencilla:
PGT-A (Test Genético Preimplantacional para Aneuploidías)
Es la técnica más común en los procesos de gestación subrogada. Su objetivo es contar los cromosomas para ver si el número es correcto.
- ¿Qué busca?: Errores en la cantidad. Los seres humanos tenemos 46 cromosomas (23 del padre y 23 de la madre). Si falta uno o sobra uno (como en el Síndrome de Down, donde sobra el cromosoma 21), el test lo detecta.
- La analogía del libro: Aquí solo contamos si el libro tiene las 46 páginas que debería tener. No leemos lo que dicen las frases, solo miramos que no falte ninguna hoja ni haya hojas repetidas.
- ¿Para quién es?: Para mujeres de más de 35 años, parejas con abortos previos o simplemente para asegurar que el embrión es cromosómicamente sano.
PGD o PGT-M (Test Genético Preimplantacional para Enfermedades Monogénicas)
Antes se llamaba siempre PGD, pero ahora los médicos prefieren llamarlo PGT-M. Se usa cuando los padres saben que son portadores de una enfermedad específica que no quieren transmitir a su hijo.
- ¿Qué busca?: Una enfermedad concreta (como la Hemofilia).
- La analogía del libro: Aquí no solo contamos las páginas, sino que vamos a una página y línea específica para ver si hay una falta de ortografía (una mutación) que cause una enfermedad.
- ¿Para quién es?: Para familias con antecedentes de enfermedades hereditarias graves.
NGS (Next Generation Sequencing)
A diferencia de las anteriores, la NGS no es un test en sí mismo, sino la tecnología (la máquina) que se usa para hacer los análisis anteriores.
- ¿Qué es?: Es la técnica de «Secuenciación de Nueva Generación». Es como pasar de usar una lupa antigua a usar un escáner láser ultra potente y digital.
- ¿Qué hace?: Permite leer el ADN de forma masiva, rápida y mucho más barata que antes. Es tan precisa que puede detectar incluso el mosaicismo (cuando un embrión tiene algunas células sanas y otras no).
- La analogía del libro: Es el tipo de escáner de alta definición que usamos para revisar el libro.
Resumen rápido para tu proceso de gestación subrogada:
| Sigla | ¿Qué es? | Función principal |
| PGT-A | El examen | Cuenta si hay 46 cromosomas (evita Down, Turner, etc.). |
| PGD (PGT-M) | El examen | Busca una enfermedad específica de los padres. |
| NGS | La tecnología | Es la máquina moderna que hace que el PGT-A sea ultra preciso. |
Un dato importante: En la mayoría de las clínicas de maternidad subrogada actuales, cuando pides un «PGT-A», casi siempre te lo harán utilizando tecnología NGS, porque es el estándar de calidad más alto hoy en día.